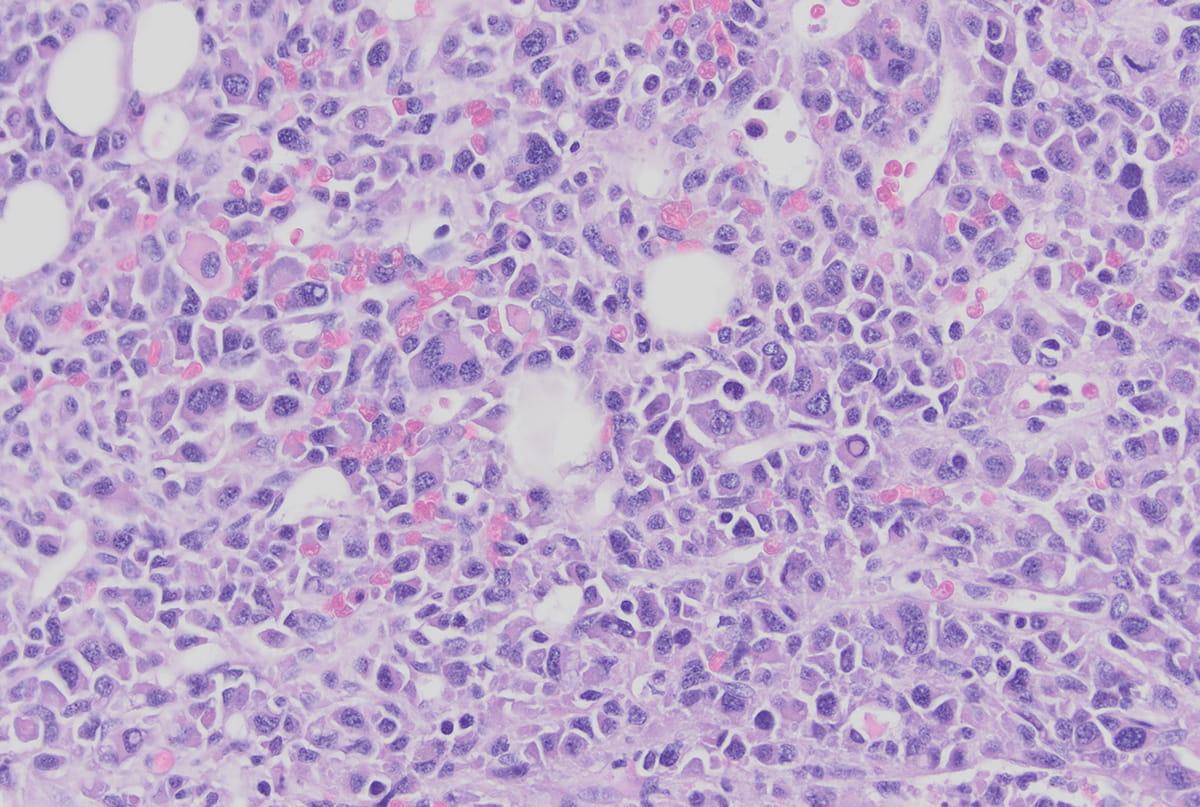
microscopy image of myeloma in plasma cells

Showing results for Winter 2024
-
![water color painted portraits of the alumni award winners who include Mason Goodman, Sharon Singleton, Daniel Hayes, Richard Rink, Allison Brashear, and Brandon Brown.]()
The Difference Makers
IU School of Medicine recognizes graduates whose work recognizes its enduring message to provide compassionate care, train future healers, and use research to transform health. ...
Bobby King | Jan 19, 2024 -
![a red and white indy car race car is parked in front of the pagoda suites at the indianapolis motor speedway. A billboard in the background reads "Chip Ganassi Racing" and "Indiana University Melvin and Bren Simon Comprehensive Cancer Center"]()
Getting Cancer Research on Track
A slick paint job on a quick car zooming around an iconic venue brought attention to vital research unfolding at IU Simon Comprehensive Cancer Center. ...
Bobby King | Dec 21, 2023 -
![microscopy image of myeloma in plasma cells]()
Tracing the Story of Myeloma
The Indiana Myeloma Registry charts new variables of the disease in pursuit of more effective therapies.
Matthew Harris | Dec 21, 2023 -
![liana apostolova sits across a table from a woman who is a participant in the LEADS study. Apostolova holds a flash card for the woman to read.]()
Leading the Way
A landmark IU School of Medicine study of early-onset Alzheimer’s disease enters its fifth year — and has more insights to share.
Laura Gates | Dec 13, 2023 -
![Matt Rutz walks down a hospital hallway filled with hospital beds on wheels. He is wearing dark blue scrubs.]()
State of Emergency
IU School of Medicine strives to address burnout, mental health stressors and gender inequities faced by emergency medicine physicians.
Matthew Harris | Dec 13, 2023 -
![microscopic sample of brain tissue in light blue, green and black colors with swirling pattern]()
Alzheimer’s Holy Grail
Finding a biomarker for Alzheimer's disease is the field's holy grail. Jeff Dage, PhD, has been searching for most of the past decade.
Matthew Harris | Dec 13, 2023 -
![Ted Kitchel boxes against a dummy in the gym. He has short cropped white hair, a black t shirt and black boxing gloves.]()
Fighting Back
Former IU basketball star Ted Kitchel takes his fight against Parkinson’s disease seriously – in the gym to keep his motor skills sharp and outside ...
Bobby King | Dec 13, 2023